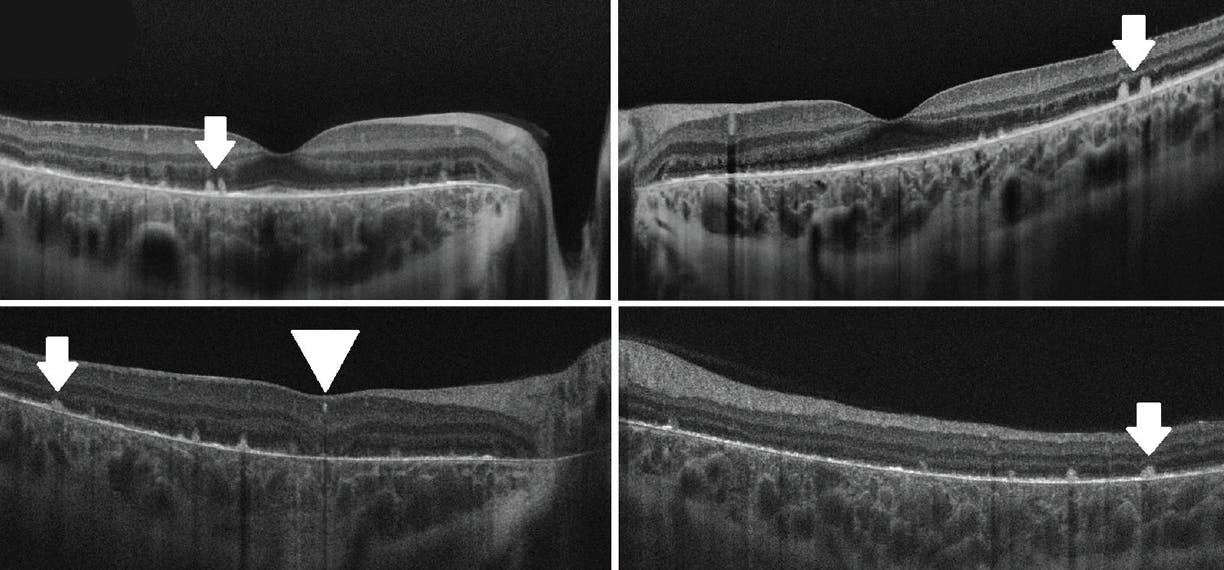

A 12-year-old girl presented to our clinic with poor vision at night. Her BCVA was 20/25 OD and 20/25 OS, and she had a family history of hereditary retinal dystrophy.
The anterior segment examination of each eye was unremarkable. Color fundus photography revealed diffuse, glistening, yellow-white crystalline deposits at the posterior pole of the retina in each eye (Figure 1). Fundus autofluorescence (FAF) also showed hyperautofluorescent deposits at the posterior pole of each eye (Figure 2).
OCT revealed hyperreflective spots (Figure 3, white arrowhead) in the inner retinal layers, bright reflective deposits (white arrow) on top of the retinal pigment epithelium (RPE)-Bruch membrane complex, and absence of outer retinal tubulations in each eye. Disruption of the ellipsoid zone, interdigitation zone, and RPE was more prominent on the parafoveal OCT sections. Presence of prominent crystalline retinal deposits, along with FAF and OCT findings, led us to the diagnosis of early-stage Bietti crystalline dystrophy (BCD).
DISCUSSION
BCD is an uncommon progressive retinal degenerative disease that has an autosomal recessive inheritance pattern. Mutation of the CYP4V2 gene leads to defective fatty acid metabolism in the RPE and formation of retinal deposits.1-3
The presentation usually occurs between the second and third decades of life. The initial symptoms of BCD include gradual reduction in visual acuity, decreased night vision, and visual field loss.
The glistening yellow-white retinal crystalline deposits that are evident in the early stages of the disease are gradually replaced by RPE atrophy.4,5 Because our patient’s case was at a very early stage of the disease, the crystalline deposits were more prominent and outer retinal tubulations were absent.
Although the diagnosis of BCD is mainly based on the presence of distinctive retinal crystalline deposits, multimodal imaging techniques, such as OCT and FAF, are also useful to elucidate the diagnosis and disease course.
If you have an image or images you would like to share, email Dr. Nagpal.
Note: Photos should be 400 dpi or higher and at least 10 inches wide.
1. Nakamura M, Lin J, Nishiguchi K, Kondo M, Sugita J, Miyake Y. Bietti crystalline corneoretinal dystrophy associated with CYP4V2 gene mutations. Adv Exp Med Biol. 2006;572:49-53.
2. Rossi S, Testa F, Li A, et al. Clinical and genetic features in Italian Bietti crystalline dystrophy patients. Br J Ophthalmol. 2013;97(2):174-179.
3. Ilhan A, Yolcu U. Re: Halford et al. Detailed phenotypic and genotypic characterization of Bietti crystalline dystrophy. Ophthalmology. 2014;122(4):e22.
4. Yuzawa M, Mae Y, Matsui M. Bietti’s crystalline retinopathy. Ophthalmic Paediatr Genet. 1986;7(1):9-20.
5. García-García GP, Martínez-Rubio M, Moya-Moya MA, Pérez-Santonja JJ, Escribano J. Current perspectives in Bietti crystalline dystrophy. Clin Ophthalmol. 2019;13:1379-1399.